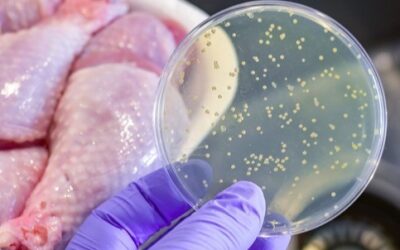

A probléma: Rejtett fertőzések és állandó fáradtság Gyakran megfázol? Vagy fáradtnak érzed magad ok nélkül? Fertőzések, gyulladás és kimerültség sok…
Author: admin

A világ legjobb citromos desszertje – egyszerű, puha és elolvad a szádban.
A citromos sütemény örök klasszikus, ami sosem megy ki a divatból. Ez a recept nem csak egyszerűségében tűnik ki, hanem…
A csirke ezen 4 mérgező része erősen szennyezett parazitákkal, mégis sokan továbbra is megeszik őket. Légy óvatos, és ne hagyd figyelmen kívül a figyelmeztetéseket, amíg nem túl késő
A csirke ezen 4 mérgező része erősen szennyezett parazitákkal, mégis sokan továbbra is megeszik őket. Légy óvatos, és ne hagyd…

Kedvenc sütink: Mézes krémes… Szeletelés előtt!
Bármelyik ünnepen de hétköznapokon is mennyei. Barátnőm receptje szerint, nekünk ez nagyon bevált. Ünnepekre remek választás, ez egy valódi hagyományos…

A fülünk elárulja egészségi állapotunkat
A fülünk elárulja egészségi állapotunkat 👂✨ Az emberi test működése sosem hagyja abba, hogy lenyűgözzön minket. Valójában képes jeleket küldeni,…

Egyszerű trükk a sütőajtó üvegének tisztításához
A sütőajtó tisztítása – különösen az üveglapok közötti rész – komoly kihívást jelenthet. Idővel zsír és ételmaradékok halmozódnak fel, ami…

Hogyan tároljuk a tojásokat hűtőszekrény nélkül? A múltból ismert, bevált módszerek, amik ma is működnek!
Bevált hagyományos módszerek, amelyek ma is működnek Bevezetés A mai háztartásokban a hűtőszekrény szinte elengedhetetlen, de mi történik akkor, ha…

A legfinomabb sörkifli recept
Hozzávalók: 50 dkg liszt 3 dl tej

Olaj, SOHA ne dobd ki a dugónak ezt a részét: nagyon fontos | Pontosan erre való. teljes recept
Amikor egy üveg olajat nyitunk ki, szinte mindenki automatikusan eltávolítja a kupak belsejében található műanyag gyűrűt, és egyszerűen kidobja. Pedig…
